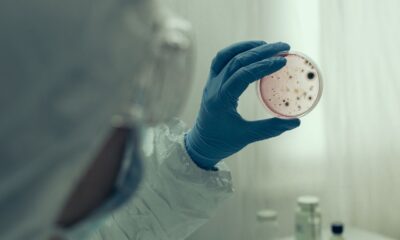

El mundo “continúa en pandemia de COVID-19, mientras el virus sigue evolucionando”, advirtió la jefa técnica de la Organización Mundial de la Salud contra esta enfermedad,...



Más de 5 millones de casos de dengue han sido reportados en el mundo, entre ellos 5 mil mortales, indicó la Organización Mundial de la Salud...



En pleno 2023 la Organización Mundial de la Salud (OMS) encendió las alertas en todo el mundo, esto debido a un brote masivo de ántrax en...



Se viene una nueva campaña de vacunación contra COVID en México y en medio del reconocimiento con el Premio Nobel de Medicina a los creadores de la...



Con la llegada cada vez más cercana del invierno, la Organización Mundial de la Salud (OMS) dio un aviso sobre sus crecientes preocupaciones sobre el COVID-19,...



Los casos de COVID-19 experimentaron un aumento del 80 por ciento en las últimas cuatro semanas (del 10 de julio al 6 de agosto), debido principalmente...



La Organización Mundial de la Salud (OMS) está siguiendo en la actualidad algunas variantes del coronavirus, incluida la EG.5 que se está propagando por Estados Unidos...



En el mes pasado, solo un 25 por ciento de los países en el mundo comunicaron muertes por COVID-19, y un porcentaje aún menor, del 11...

La Organización Mundial de la Salud (OMS) alertó este viernes 19 de mayo de un aumento alarmante de brotes de cólera en el mundo -principalmente en...



La Organización Mundial de la Salud (OMS) declaró el final de la emergencia internacional por el brote de viruela símica, declarada en julio del pasado año...